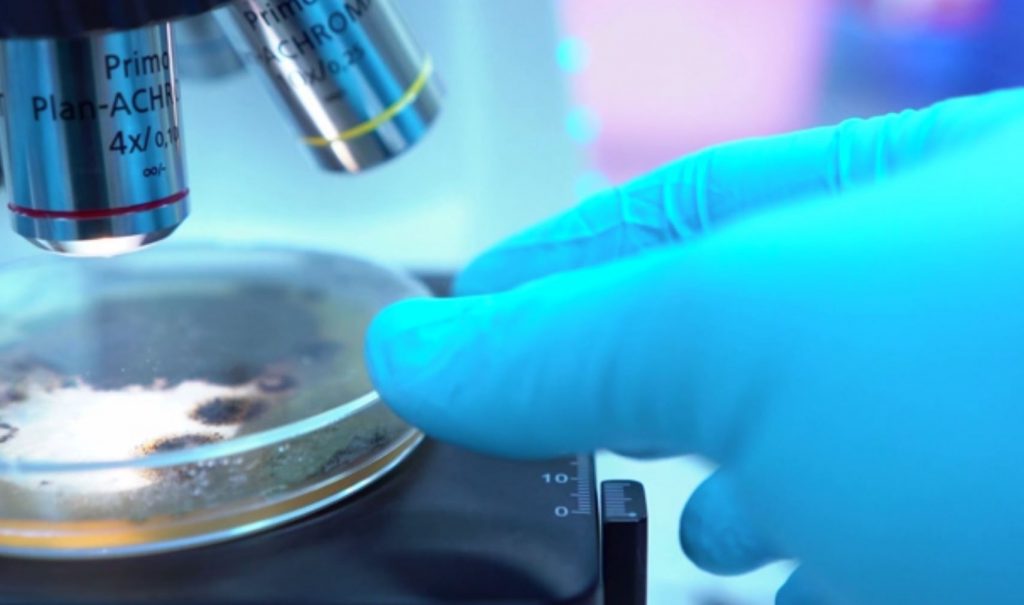

Εκατόν έξι χρόνια συμπληρώνονται από το ιστορικό έγκλημα που συντελέστηκε με την εξόντωσης των Αρμενίων από τη Οθωμανική Αυτοκρατορία. Η Ελλάδα τίμησε την επέτειο, ενώ υπάρχει μία εξέλιξη ιστορικής σημασίας, η αναγνώριση της γενοκτονίας από τις Ηνωμένες Πολιτείες.
Η πολυαναμενόμενη αναγνώριση της Γενοκτονίας τω Αρμενίων από τις ΗΠΑ αναμένεται να προκαλέσει ισχυρότατο σοκ στην Τουρκία διευρύνοντας ακόμα περισσότερο το ήδη μεγάλο ρήγμα που υπάρχει στις σχέσεις Ουάσιγκτον και Άγκυρας.
ΣΤΟ ΠΛΕΥΡΟ ΤΩΝ ΑΡΜΕΝΙΩΝ Η ΕΛΛΑΔΑ
Εκατόν έξι χρόνια συμπληρώνονται από τις απαρχές της συστηματικής εξόντωσης των Αρμενίων από τη Οθωμανική Αυτοκρατορία που το 1915 βρισκόταν στα τελευταία της.
Η Ελλάδα τίμησε την μνήμη των θυμάτων της τουρκικής θηριωδίας.
Στεφάνι στο Μνημείο του Αγνώστου Στρατιώτη κατέθεσε η Κατερίνα Σακελλαροπούλου, στο πλαίσιο των εκδηλώσεων της Ελληνικής Δημοκρατίας για την επέτειο της Γενοκτονίας των Αρμενίων
«Ημέρα Μνήμης της Γενοκτονίας των Αρμενίων: 106 χρόνια από το έγκλημα του 1915, η ανθρωπότητα δεν ξεχνά το ξεκλήρισμα ενός λαού. Ένα έγκλημα μαζικό και συστηματικό, που, μάλιστα, οργανώθηκε όταν τα βλέμματα του πλανήτη ήταν στραμμένα στα λασπωμένα χαρακώματα του Α΄ Παγκοσμίου Πολέμου.»
«H Γενοκτονία των Αρμενίων αποτελεί μία από τις πιο ειδεχθείς σελίδες της παγκόσμιας ιστορίας, ζωντανή στη μνήμη των Ελλήνων που συνδέονται με τον αρμενικό λαό με δεσμούς αιώνων.»
Πέρα από την κυβέρνηση και την αξιωματική αντιπολίτευση και τα υπόλοιπα κόμματα έστειλαν μηνύματα για την ημέρα μνήμης της Γενοκτονίας των Αρμενίων
Οι εξελίξεις στο θέμα αυτό έχουν ερεθίσει την Άγκυρα που θα θέλει να πάρει την ρεβάνς και για αυτό τον λόγο στην Αθήνα ετοιμάζονται τόσο για μια αδιέξοδη 5μερη για το Κυπριακό στη Γενεύη την Τρίτη όσο και για θερμό καλοκαίρι.